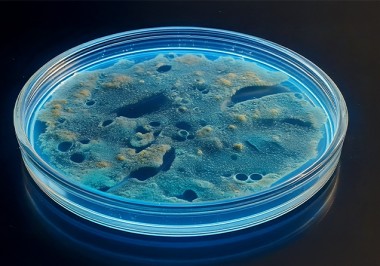
certania_microbiologytesting certania_microbiologytesting
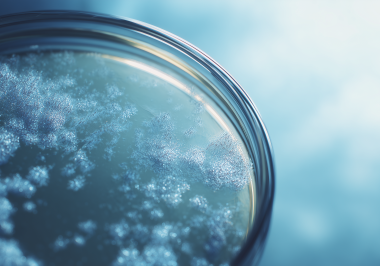
260120_CERTANIA_GroupeIcare_AI_PetriDishBacteria 260120_CERTANIA_GroupeIcare_AI_PetriDishBacteria

Service Segments
Our expertise essentially covers five areas:
Life Sciences
Our service segment Life Sciences focuses on researching pharmaceuticals, medical devices, and healthcare diagnostics. The CERTANIA network upholds rigorous scientific standards and meets international requirements.
Food & Consumer Goods
We safeguard the safety and quality of food and consumer goods with independent testing, inspection, and certification services. Our experts deliver thorough microbiological and chemical analyses, and inspections aligned with Good Agricultural Practice (GAP) guidelines.
Industrials
From material testing to renewable energy certification, we provide comprehensive testing, inspection, and certification services. Our expertise enables companies in the automotive, industrial, and energy sectors to consistently achieve the highest standards of performance and quality.
Buildings & Infrastructure
We provide comprehensive inspection, testing, and analytics for buildings, infrastructure and environments – ensuring safety, quality and compliance in materials, air, soil, and sports facility.
Certification & Compliance
Our specialized services ensure that your products and services meet the highest standards. We provide a comprehensive suite of offerings, including auditing, certification, and consulting, to safeguard compliance in areas such as sustainability, quality, and ESG.